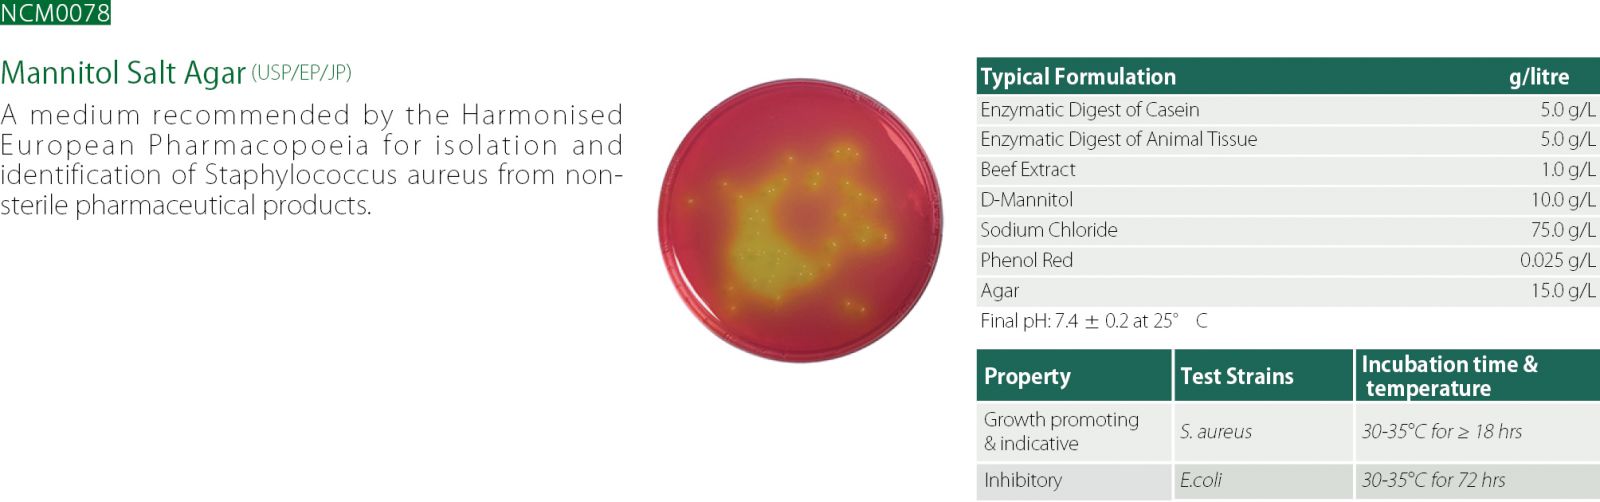
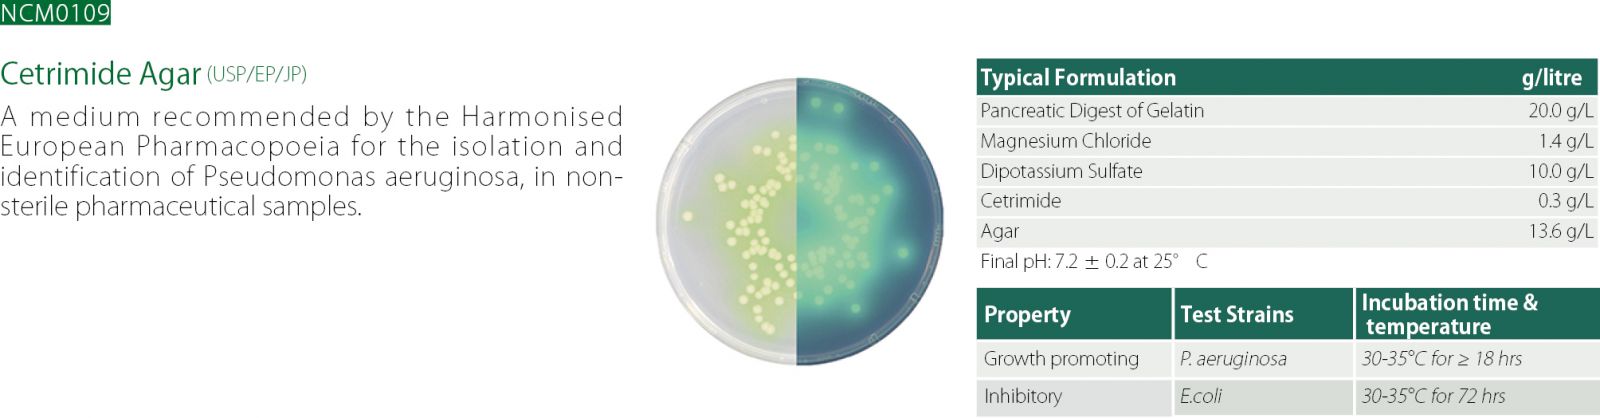

產品介紹
Neogen NCM 專業微生物培養基
NCM 藥廠專用培養基
藥廠專用培養基
 |
產品說明:
藥廠專用培養基
遵循USP/EP/JP藥典專用粉末培養基
品保遵循ISO 9001:2008品質管理系統
國際標準規範NEOGEN是您最佳選擇! |
| 產品名稱 : 藥廠專用培養基 |
►產品介紹
自1978年以來Acumedia一直被視為高品質粉末培養基的領導廠商,其應用範圍廣及藥廠、
生物科技以及生命科學研究開發之領域。
產品精緻質優,符合科學家及研發人員喜愛廣泛使用。
▪廣口式的設計-易於堆疊、節省空間、利於清潔整理,轉角死、避免黴菌汙染。
▪粉末細緻,快速溶解。
▪客製化包裝及大包裝,滿足產業界品管生產不同的需求。
▪機械工業化製程,無人為及人工的汙染與失誤。
▪Neogen Culture Media客製化的服務透過經驗豐富的RD團隊與有效率的操作給予客戶的
承諾經營。
▪承諾客戶提供維持足夠的存貨以滿足其需求。
▪提供專業的技術資源。
▪承諾以ISO9001之品質管理系統,提供客戶足夠的文件分析報告以滿足甚至超越法規與監
督的需要。
▪永遠選擇最安全與優質的原料,無BSE/TSE成分來源。
▪Neogen Culture Media承諾提供產業界領導級的服務,透過高品質粉末培養基的製造,以
此維護品牌的商譽。
►產品介紹
►►Bile-tolerant Gram-negative bacteria:

►►Bile-tolerant Gram-negative bacteria:

►►Escherichia coli:
.jpg)
►►Salmonella:

►►Staphylococcus aureus:
►►Pseudomonas aeruginosa:
►►Clostridia:
.jpg)
►►Candida albicans:

►►Support media for control culture cultivation inoculum preparation:


|
| 有興趣請點選 |
 |
參觀選購 |
|
|

